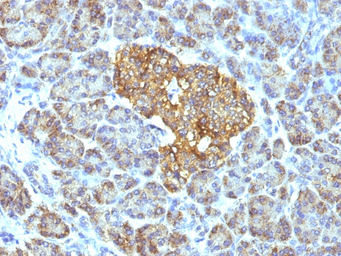
HSP60 antibody [GROEL/730]
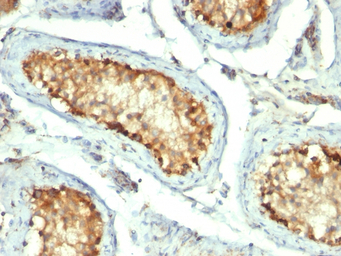
HSP60 antibody [GROEL/730]

相关产品推荐更多 >
万千商家帮你免费找货
0 人在求购买到急需产品
- 详细信息
- 文献和实验
- 技术资料
- 免疫原:
Recombinant human HSP60 protein
- 亚型:
IgG1
- 形态:
Liquid
- 保存条件:
Store as concentrated solution. Centrifuge briefly prior to opening vial. Store at 4ºC.
- 克隆性:
Monoclonal
- 标记物:
Unconjugated
- 适应物种:
Human
- 保质期:
12 months from the shipping date of the product.
- 抗原来源:
Human
- 目录编号:
GTX34787
- 级别:
Primary Antibodies
- 库存:
Available
- 供应商:
GeneTex
- 宿主:
Mouse
- 应用范围:
WB, ICC/IF, IHC-P, FACS
- 浓度:
0.2 mg/ml (Please refer to the vial label for the specific concentration.)
- 靶点:
Clone GROEL730 reacts only with human and is useful in distinguishing human hsp60 from other mammalian and bacterial hsp60.,We do not recommend use of this product for Mouse,Rat.
- 抗体英文名:
HSP60 antibody [GROEL/730]
- 抗体名:
HSP60 抗体 [GROEL/730]
- 规格:
100 μg

ICC/IF analysis of HeLa cells using GTX34787 HSP60 antibody [GROEL/730].
Green : Primary antibody
Red : nucleus

WB analysis of HeLa cell lysate using GTX34787 HSP60 antibody [GROEL/730].
IHC-P analysis of human pancreas tissue using GTX34787 HSP60 antibody [GROEL/730].
IHC-P analysis of human testicular carcinoma tissue using GTX34787 HSP60 antibody [GROEL/730].

IHC-P analysis of human tonsil tissue using GTX34787 HSP60 antibody [GROEL/730].
风险提示:丁香通仅作为第三方平台,为商家信息发布提供平台空间。用户咨询产品时请注意保护个人信息及财产安全,合理判断,谨慎选购商品,商家和用户对交易行为负责。对于医疗器械类产品,请先查证核实企业经营资质和医疗器械产品注册证情况。
 文献和实验
文献和实验De Maio F et al., Virulence 2021 (PMID:33757409)
上海西唐生物科技有限公司 021-55229872, 65333639 www.westang.com 人热休克蛋白60 ( HSP60 )ELISA 试剂盒 原理 本实验采用双抗体夹心 ABC-ELISA 法。用抗人 HSP60 单抗包被于酶标板上,标准品和样品中的 HSP60与单抗结合,加入生物素化的抗人 HSP60 ,形成免疫复合物连接在板上,辣根
GroEL. I. GroEL recognizes the signal sequences of beta-lacta-mase precursor. J . Mol. Biol. 24 2, 150-164. 44. Freeh, C. , Wunderlich, M. , Glockshuber, R. , and Schmid, F. X. ( 1 99 6 ) Competition between DsbA-mediated
. Kammermeier, J. Buchner, BIP and PDI cooperate in the oxidative folding of antibodies in vitro, J. Biol. Chem. 275 (2000) 29421-29425. 41. X. Dong, H. Yang, Y. Sun, Lysozyme refolding with immobilized GroEL column chromatography, J. Chromatogr. A 878 (2000
 技术资料
技术资料暂无技术资料 索取技术资料





![ING1 antibody [C1C3]](https://img1.dxycdn.com/2023/0711/255/2344116916935858761-14.jpg!wh200)
![Survivin antibody [Mix]](https://img1.dxycdn.com/2023/0711/451/6106825198874858761-14.jpg!wh200)

